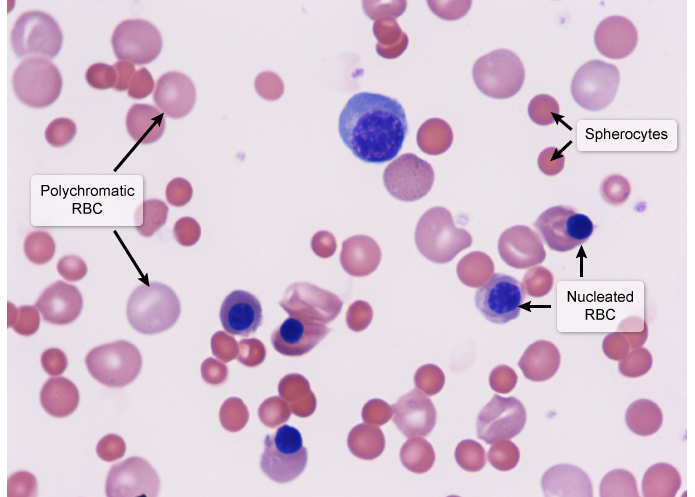

G6PD deficiency can be differentiated from other hemolytic anemias by the presence of — bodies (inclusions of denatured hemoglobin) and — cells (caused by phagocytic removal of Heinz bodies) on peripheral smear.
Heinz
bite
Glucose-6-phosphate dehydrogenase deficiency presents with signs of normocytic anemia (eg, fatigue, pallor) and hemolysis (eg, jaundice, dark urine) after oxidative stress (eg, sulfa drug). Hemolysis is associated with increased/decreased reticulocytes, increased lactate dehydrogenase, decreased haptoglobin, and elevated indirect bilirubin, which manifests as jaundice and scleral icterus.
increased
Hereditary spherocytosis is caused by defective binding of the red cell cytoskeleton to the plasma membrane due to mutations involving a —,—,— proteins; acquired spherocytosis is most often caused by autoimmune hemolytic anemia.
In spherocytosis, mean corpuscular hemoglobin concentration (MCHC) is increased due to mild dehydration of the red blood cell. Markers of hemolysis are often evident and include elevated lactate dehydrogenase, reticulocytosis, and decreased haptoglobin.
ankyrin, band 3, or spectrin
This patient with untreated systemic lupus erythematosus (SLE) has normocytic anemia with low serum iron and low total iron-binding capacity, raising strong suspicion for —- anemia. Most cases arise in those with chronic elevation of inflammatory cytokines due to underlying rheumatologic disease (eg, SLE), chronic infection, or malignancy. primary mediator is hepcidin, a small peptide released by the liver in response to inflammation.
There is iron sequesterating in macrophages
Labs: normocytic or slightly microcytic anemia with low reticulocyte response, low serum iron level, and normal or low total iron-binding capacity.
anemia of chronic disease (ACD)
Acute intermittent porphyria is an autosomal dominant condition caused by porphobilinogen deaminase deficiency. Most patients remain asymptomatic, but a minority present with acute attacks characterized by abdominal pain and vomiting, peripheral neuropathy, neuropsychological symptoms, and reddish-brown urine that darkens on exposure to light and air due to the oxidation of excess PBG.. Treatment consists of intravenous glucose or heme preparations, which downregulate —- activity.
ALA synthase
—– of hemoglobin occurs in sickle cell anemia. A missense mutation in the beta globin chain leads to the production of hemoglobin S, which has the capacity to polymerize in deoxygenated states. This polymerization leads to red blood cell membrane injury and deformation to a “sickle” shape seen on peripheral smear.
Polymerization
Heredity spechycytosis, is due to a —-. Clinical manifestations include hemolytic anemia, jaundice (increased RBC destruction results in greater bilirubin production), and splenomegaly. Infections can trigger hemolysis and lead to an acute hemolytic crisis.
red blood cell (RBC) membrane defect
The triad of hemolytic anemia, hypercoagulability, and pancytopenia suggests paroxysmal nocturnal hemoglobinuria (PNH). PNH results from an acquired mutation in the PIGA gene that causes absence of the glycosylphosphatidylinositol anchor and associated deficiency of —- and — complement inhibitor proteins.
CD55 and CD59
Schistocytes are fragmented parts of RBCs formed from mechanical hemolysis via sheer force of blood flow. Hemolytic uremic syndrome, ___, and ____ all present with schistocytes.
thrombotic thrombocytopenic purpura
disseminated intravascular coagulation
Lead inhibits the heme synthesis pathway (δ-aminolevulinate dehydratase and ferrochelatase), causing a microcytic, hypochromic anemia. Shortness of breath, particularly with exertion occurs. Iron studies are normal unless co-existing iron deficiency is present as well. Basophilic stippling is frequently seen on peripheral blood smear. Inhibition of —— by lead results in ribosome aggregation due to inability to degrade RNA, which is represented by coarse blue punctate dots in the cytoplasm of red blood cells (RBCs).
erythrocyte 5’ nucleotidase
patient has microcytic anemia, constipation, and mental status changes in the setting of construction work. The most likely diagnosis is —poisoning
lead
Glucose-6-phosphate dehydrogenase deficiency is an X-linked disorder of the hexose monophosphate (pentose phosphate) pathway. In affected individuals, the amount of NADPH produced in RBCs is low, which impairs —–mediated inactivation of free radicals. Hemolytic episodes are induced b_y infections,_ medications (bactrim), and other oxidants.
glutathione
In patients with —- anemia, peripheral blood smear usually reveals evidence of reticulocytosis, spherocytes, and nucleated red blood cells.
hemolytic
Patients with chronic hemolytic anemia (eg, beta thalassemia major) depend on recurrent red blood cell (RBC) transfusions to maintain an adequate hemoglobin level. Iron overload (hemosiderosis) from increased iron absorption is a common complication resulting from both the primary condition (eg, hemolysis) and its treatment (frequent RBC transfusions).
hemosiderin and microscopically appears as brown or yellowish-brown pigments in either granular or crystalline form. Hemosiderin can be identified histologically with a Prussian-blue stain. In the liver, hemosiderin is typically seen in — cells (hepatic macrophages that line the walls of the sinusoids and participate in RBC breakdown).
Kupffer
Patients with Gaucher disease (—- enzyme deficiency) have pancytopenia, hepatosplenomegaly, and pathologic fractures. The cardinal histologic finding are Gaucher cells (black arrows), which are macrophages laden with cerebrosides and other glycolipids.

glucocerebrosidase
Schistocytes are diagnostic of a traumatic mechanism and indicate either —- anemia (eg, HUS, thrombotic thrombocytopenic purpura [TTP], disseminated intravascular coagulation [DIC]) or mechanical damage (eg, prosthetic valve, severely calcified valves).
microangiopathic hemolytic
Erythropoietin deficiency results in —- anemia. In addition, erythropoietin deficiency is usually seen in chronic renal failure.
normocytic, normochromic
Leukoerythroblastic peripheral smears (ie, nucleated red cells and immature white cells) are usually seen when the marrow is replaced with fibrosis (or metastatic cancer). The red cells can be squeezed while passing through fibrous strands and appear on the peripheral smear as characteristic —- cells.
teardrop
Polycythemia vera (PV) is a clonal myeloproliferative disease of pluripotent hematopoietic stem cells. Approximately 95% of patients with PV have a V617F mutation involving the —- gene, which is involved in signal transduction. This mutation replaces a valine with phenylalanine at the 617 position, rendering hematopoietic cells more sensitive to growth factors such as erythropoietin and thrombopoietin.
JAK2
—- presents with increased RBC mass, increased plasma volume, and low erythropoietin levels. Additional manifestations can include an elevated platelet and/or WBC count, thrombotic events (from blood hyperviscosity), peptic ulceration and aquagenic pruritus (due to histamine release from basophils), and gouty arthritis (from increased cell turnover). Physical examination typically shows a plethoric, reddened face and splenomegaly. Diagnosis is established by confirming low serum erythropoietin levels and bone marrow aspiration cytogenetic studies showing a JAK2 mutation. Treatment involves serial phlebotomy as necessary to keep the hematocrit < 45%.
polcythemia vera
—– cells are red blood cells with a dark center, a surrounding halo of pallor, and a dark peripheral ring. They form in erythrocytes with an excessive surface area-to-volume ratio
Target
—- cells form when erythrocytes have reduced cell volume (eg, thalassemia, iron deficiency) or excessive membrane (eg, obstructive liver disease, postsplenectomy). Patients who undergo splenectomy usually develop —cells because the spleen is the primary organ that prunes excessive red cell membrane.
Target
Paroxysmal nocturnal hemoglobinuria is due to a gene defect that leads to uncontrolled complement-mediated hemolysis. The classic triad includes hemolytic anemia (hemoglobinuria), pancytopenia, and thrombosis at atypical sites. Chronic hemolysis can cause —– deposition in the kidney (hemosiderosis).
iron
—-virus is a small, nonenveloped, DNA virus transmitted via the respiratory route that primarily attacks erythroid progenitor cells due to tropism for an erythrocyte cell surface receptor (P blood group antigen). Infection of erythroid progenitor cells prevents red blood cell maturation, leading to formation of abnormal giant pronormoblasts (several times larger than surrounding red blood cells) with glassy, intranuclear viral inclusions. The drop in red cell production often leads to a transient (1-2 week) drop in hematocrit. Although many patients are asymptomatic, individuals with underlying hemoglobin disorders (eg, sickle cell anemia) sometimes develop symptomatic anemia.
Parvo



